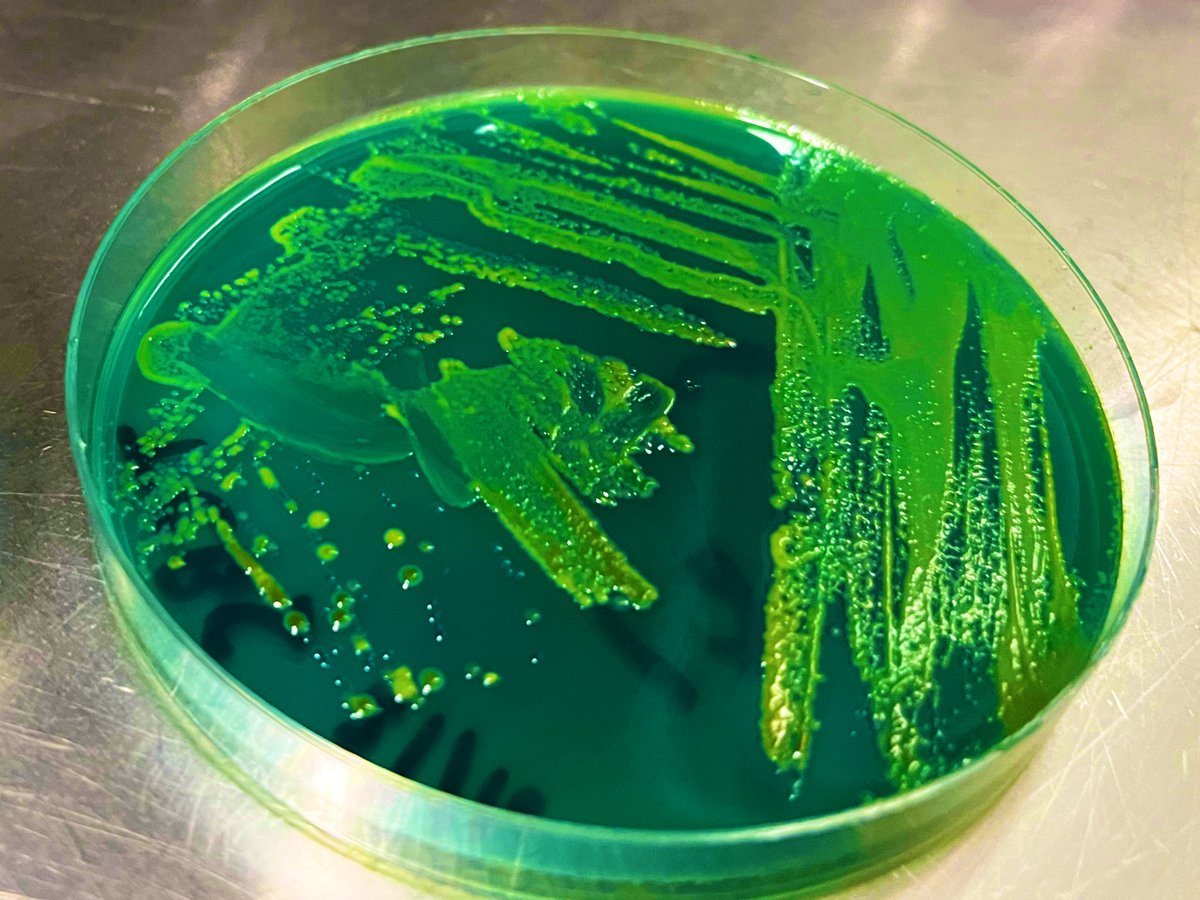
LEAF_AUB tweet media

고정된 트윗

In the event of the #Cholera #outbreak in #Lebanon, LEAF is now offering testing for Cholera in water and environmental samples.
For more information, please contact us at leaf@aub.edu.lb or 01350000 x 4824
@mophleb @WHOLebanon @dr_abiad @AUBMC_Official @POAUB @AUB_FAFS
English

























